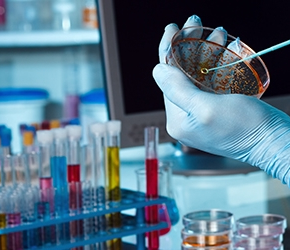
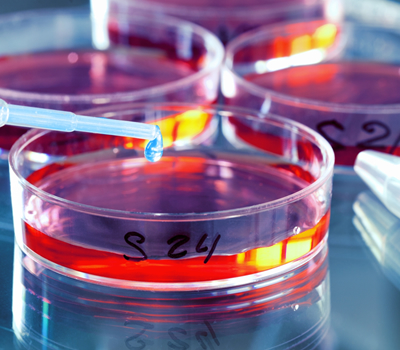
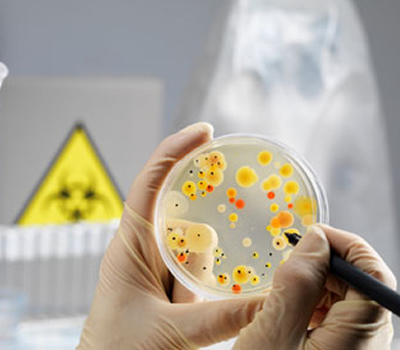

Customer Service
When faced with a difficult request, it can be easy to decline an offer. We, however, see all projects as an opportunity to maximize our expertise and work at carefully listening to our customers in order to best meet their needs. ("Customer-Oriented / Solution-Driven")